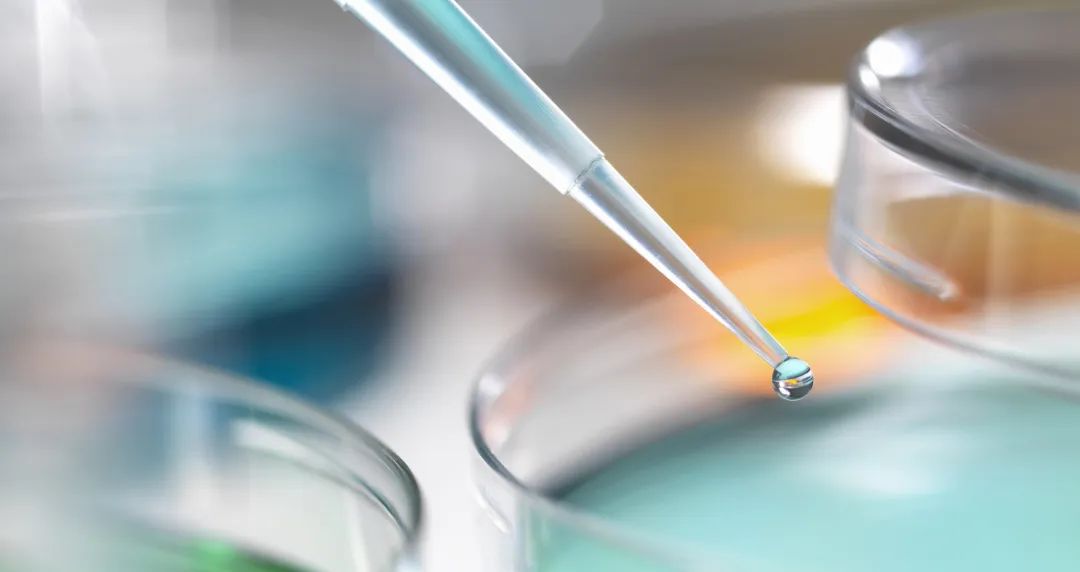
undefined

怀孕后,既兴奋又担心。
兴奋即将为人母,又担心产检有意外。
但是,孕妈妈做的每一项检查都是为了更好地和宝宝相遇~
对于产检,虽然可能每家医院都会有一些不同,但是到了孕中期,有一项检查是产检医生一定会建议孕妈们做的。
“唐氏筛查”
唐氏筛查是什么?
唐氏筛查是通过抽取孕妈妈的血清,检测其中的各项指标,并结合孕妈妈的预产期、年龄、体重等信息,计算出生育先天愚型胎儿的危险系数。
根据不同的孕期相关指数要求,一般可以分为早期唐筛(一般在11-13周)和中期唐筛(一般在15-20周),其中运用更广泛的是中期唐筛。
先天愚型胎儿,细胞分裂的失误
正常情况下,人有46条(即23对)染色体,其中21三体和18体,就是先天愚型胎儿的出现原因。
简单来说就是在父母其中一方生殖细胞分裂时,本应该平均分配到两个细胞的一对染色体没有按照计划分开,导致一个细胞多一条,另一个细胞少一条。
少一条染色体的我们称之为单体,单体的胎儿基本都在妊娠早期流产;而多一条染色体就是我们所说的三体。其中21三体,就是咱们常说的唐氏儿。
在唐氏儿中,有一部分能够顺利的来到这个世界,甚至成长起来,但是他们除了面容和举止异于常人外,大多数都存在一定的智力障碍(平均智商50,正常的儿童平均智商100)。另外,还有很多疾病的发病率会高于普通儿童,比如:先天性心脏病、白内障、白血病等等。
这一切对于孩子,对于家庭都是十分不利,也是十分不公平的。
很不幸,每个孕妈妈都有可能生育唐氏儿
生育唐氏儿,并不是遗传性疾病,而是属于生殖过程中的突发事件,每个孕妈妈都可能生育唐氏儿。
在我国:
25岁以下的孕妈生育唐氏儿的概率为1/1300;
35岁的孕妈妈其概率高达1/365(国内大多数医院的唐氏筛查高危风险值为1/270);
45岁的孕妈妈其概率甚至达到了1/30。
从数据来看,似乎越年轻的孕妈妈越安全,其实不然,80%的唐氏儿都是由35岁以下的孕妈妈所生。
因此,唐氏筛查,对于每个孕妈妈而言,都是极有意义的。
唐筛的结果是几率,不是诊断
唐筛筛查做起来很简单,孕妈妈只需要当天行超声检查,并抽静脉血送检就行了,剩下的交给实验室就好了。
实验室会计算出孕妈妈生育唐氏儿的风险,但是风险高并不代表一定会生育出唐氏儿,风险低就一定不会。因此很多人会觉得,这不就等于白做吗?
其实唐氏筛查就是用有限的资源最大限度的区分高风险和低风险的孕妈妈,还是能够很大程度降低唐氏儿出生风险的。
当然,如果还是担心自己生育出唐氏儿,那可以选择高级别的筛查。如果唐氏风险很高的孕妈妈,那一定要做进一步检查。
一般来说有两种检查方法:
01.无创DNA
无创DNA是通过采取孕妇的血液,提取孕妇血液中胎儿的DNA片段进行鉴定胎儿染色体有无异常。无创DNA检测21三体的准确率可以达到99%,并且对于孕妇和胎儿都是很安全的。
02.羊水穿刺
羊水穿刺是在超声检测下用长针穿刺进羊膜腔吸出部分羊水,对羊水中的胎儿脱落细胞进行培养检测,制片、染色后在显微镜下进行胎儿染色体的核型分析,是目前诊断唐氏的金标准。它的准确率接近100%。
不过由于羊水穿刺属于一种有创检查,并且存在宫腔感染、流产等风险,所以很多孕妇都对它望而却步。其实这些并发症的风险非常低,甚至比生育唐氏儿的几率还低。
唐氏筛查流程图
事实上,大部分唐氏筛查高危的孕妈妈进行进一步检查后,都排出了唐氏或其他疾病,最后都顺利生下了健康的宝宝。
撰文专家
徐常恩,普通生理产科,副主任医师。
专业擅长:擅长孕产妇保健、产程的管理、难产的处理,如疤痕子宫阴道分娩、臀位外倒转等。
编辑:朱佳伟
责任编辑:李伶
声明:转载此文是出于传递更多信息之目的。若有来源标注错误或侵犯了您的合法权益,请作者持权属证明与本网联系,我们将及时更正、删除,谢谢。





)
)
)
)
